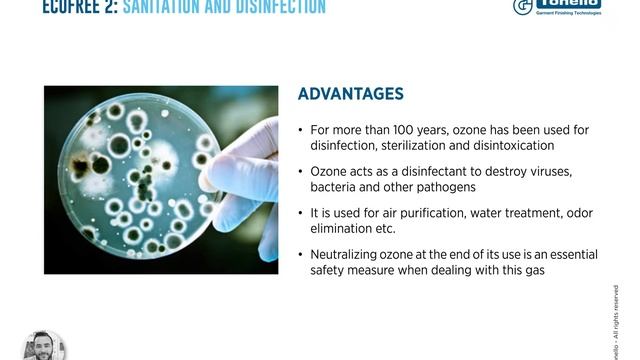
Tonello and The Laundry (R)Evolution @Kingpins24 смотреть онлайн

Автор / Канал: Лекторская атмосфера Страница 17

Подсолнух 2014 Гимназия 177 Екатеринбург
![COPYCAT ⌀ pokémon amv/pmv remake ⌀ 10K SPECIAL [flash warning] смотреть онлайн COPYCAT ⌀ pokémon amv/pmv remake ⌀ 10K SPECIAL [flash warning] смотреть онлайн](https://pic.rtbcdn.ru/video/2024-12-21/04/ba/04bad0384decdab6f63a08ef63c8b8a3.jpg)
COPYCAT ⌀ pokémon amv/pmv remake ⌀ 10K SPECIAL [flash warning]

Apocalypse RDA Gen 2 & The Spartan Mech Mod By Vapor Modified Review

#stem- loop structure of# RNA #retroviruse #CSS#PPSC.biology 1 year chp:5 topic#9 in urdu-english

function of mitochondria Hindi माध्यम।class 9,10,11,th NCERT|structure&functionof mitochondria।

Fallout 4 - What's New In Next Gen Update PC

“Mist 5%”, “Smoke 5%”, and “White 5%”—what’s the difference!? Find out in the description!

The process of Evolution (Basic biology)

Дарбыздын мекени

RF - NovaGame 2.1.6.wmv

Про эксплуатацию

When you haven’t played guitar in a while

Desert Mirror Monsters | Film Explained in Hindi/Urdu Summarized हिन्दी | Movie Summarised

I_He_She_It_can_rule
Tonello and The Laundry (R)Evolution @Kingpins24

50 Best Beautiful Seeds for Minecraft 1.19.4 | Seeds 1.19 - 1.20 | Best Seeds 1.19.4 | 1.20 Seeds

Legends Never Die MASTER MIX. | Minecraft Animtion.

Боковая складка с прямыми руками

МУТАЦИЯ В "СТАНДОФ 2"

DOMINANT S06 720P 60FPS

Экзоскелет Apogee #technology #технологии #robots

Будова рослинної клітини. Біологія 6 клас.

Буду допомагати людям, поки є здоров’я Кропивничанин 30 років здає кров

духи с феромонами для мужчин в аптеке фармация
За каждым успешным каналом стоит личность, идея и сотни часов кропотливого труда. Если вы здесь, значит, автор «Лекторская атмосфера» уже сумел зацепить ваше внимание своим уникальным стилем или подачей. А мы на RUVIDEO позаботились о том, чтобы вы могли изучить весь архив его работ в максимально комфортных условиях — без лишней суеты и преград.
Почему за работами канала «Лекторская атмосфера» так интересно наблюдать? Всё просто: это честный контент, который находит отклик в сердцах зрителей. На нашем ресурсе вы можете смотреть онлайн все видео любимого автора бесплатно и в хорошем качестве. Нам важно, чтобы вы видели каждую деталь и слышали каждый нюанс, поэтому мы используем только стабильные плееры из открытых источников Rutube.
Следите за новинками канала, пересматривайте старые шедевры и открывайте для себя новые грани творчества «Лекторская атмосфера». Мы постоянно обновляем ленту, чтобы у вас под рукой всегда были самые свежие выпуски. Никаких сложных регистраций — только вы и творчество, которое вдохновляет. Приятного вам путешествия по миру авторского контента на RUVIDEO!
Видео взято из открытых источников Rutube. Если вы правообладатель, обратитесь к первоисточнику.